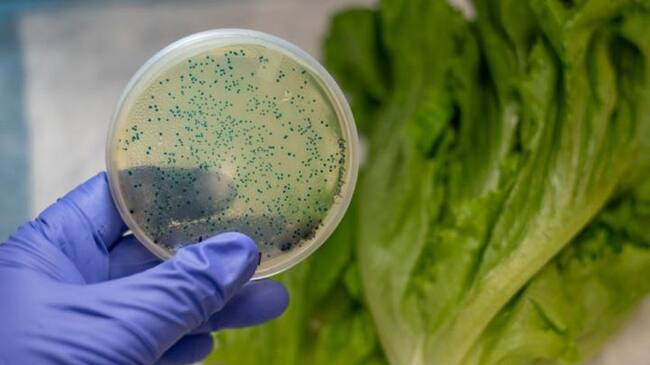
El Huila reporta 88 casos de Escherichia Coli.
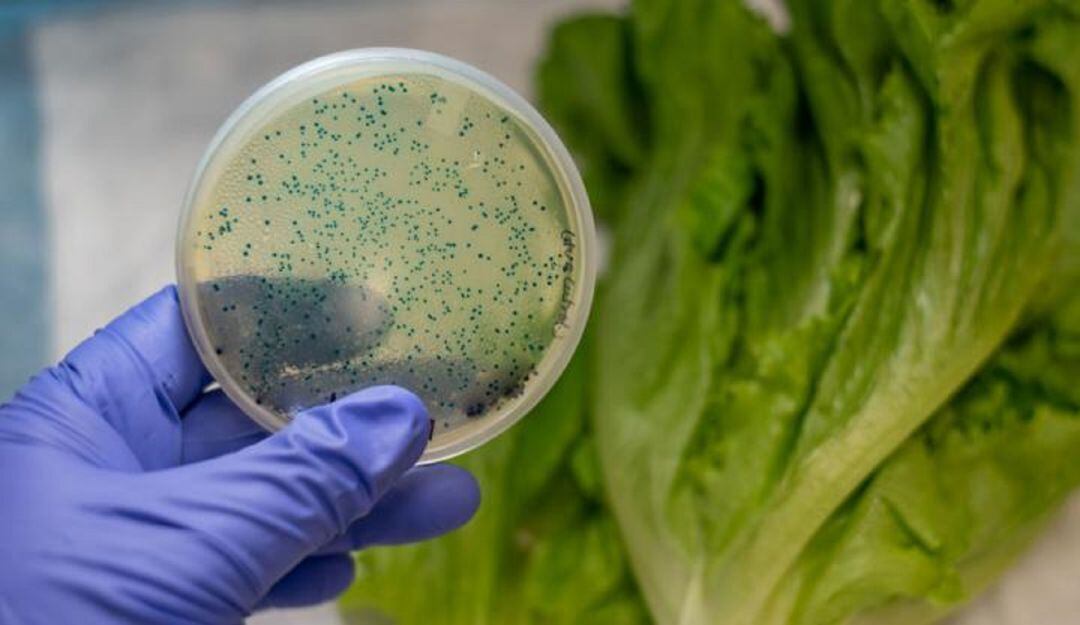
El Huila reporta 88 casos de Escherichia Coli.

El Huila reporta 88 casos de Escherichia Coli
La falta de higiene de manos ha sido causal de enfermedades transmitidas por alimentos.
El Huila reporta 88 casos de Escherichia Coli. / Secretaría de Salud Huila
A semana epidemiológica No. 36 de 2021 se han registrado 82 casos individuales y 1 colectivo de enfermedades transmitidas por alimentos, afectando a 88 personas. El 52,9% de los casos se han presentado en la ciudad de Neiva, el 10% en Algeciras y el 8,8% en Timaná.
La pandemia por coronavirus nos ha dejado como hábito el lavado frecuente de manos, una práctica que evita no solo el contagio de Covid19 sino de otras enfermedades como la diarrea y las intoxicaciones por alimentos.
Es preocupante que los más recientes casos de enfermedades transmitidas por alimentos estén relacionados con el Escherichia Coli, un microorganismo presente en la materia fecal” señaló Eduardo Mahecha Reyes, Profesional de apoyo en Vigilancia Epidemiológica de la Secretaría de Salud Departamental.
Evidentemente el lavado de manos incide en el cuidado de la salud, y es un hábito que debe practicarse con mayor frecuencia empleando jabón y dedicando buen tiempo a la limpieza de palmas, dedos y uñas.
Antes y después de utilizar el baño o el sanitario, antes y después de manipular o preparar los alimentos, antes y después de comer, antes y después de toser o estornudar, antes y después de tocar espacios comunes en áreas públicas, son buenos momentos para recordar el lavado de manos.

Francy Villarreal Ruiz
Comunicadora social y periodista egresada de la Universidad Cooperativa de Colombia en Neiva; con 18...




